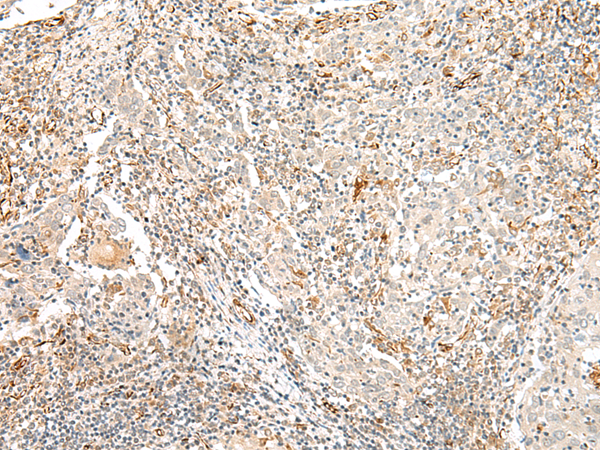

|
Background: |
Not expressed in the pons, thalamus, hypothalamus, hippocampus, caudate, putamen, frontal cortex, basal forebrain, midbrain or liver. |
|
Applications: |
ELISA, WB, IHC |
|
Name of antibody: |
TAAR2 |
|
Immunogen: |
Synthetic peptide of human TAAR2 |
|
Full name: |
trace amine associated receptor 2 (gene/pseudogene) |
|
Synonyms: |
GPR58; taR-2 |
|
SwissProt: |
Q9P1P5 |
|
ELISA Recommended dilution: |
5000-10000 |
|
IHC positive control: |
Human cervical cancer |
|
IHC Recommend dilution: |
30-150 |
|
WB Predicted band size: |
40 kDa |
|
WB Positive control: |
Human fetal brain tissue lysate |
|
WB Recommended dilution: |
500-2000 |
購物車
幫助
021-54845833/15800441009
